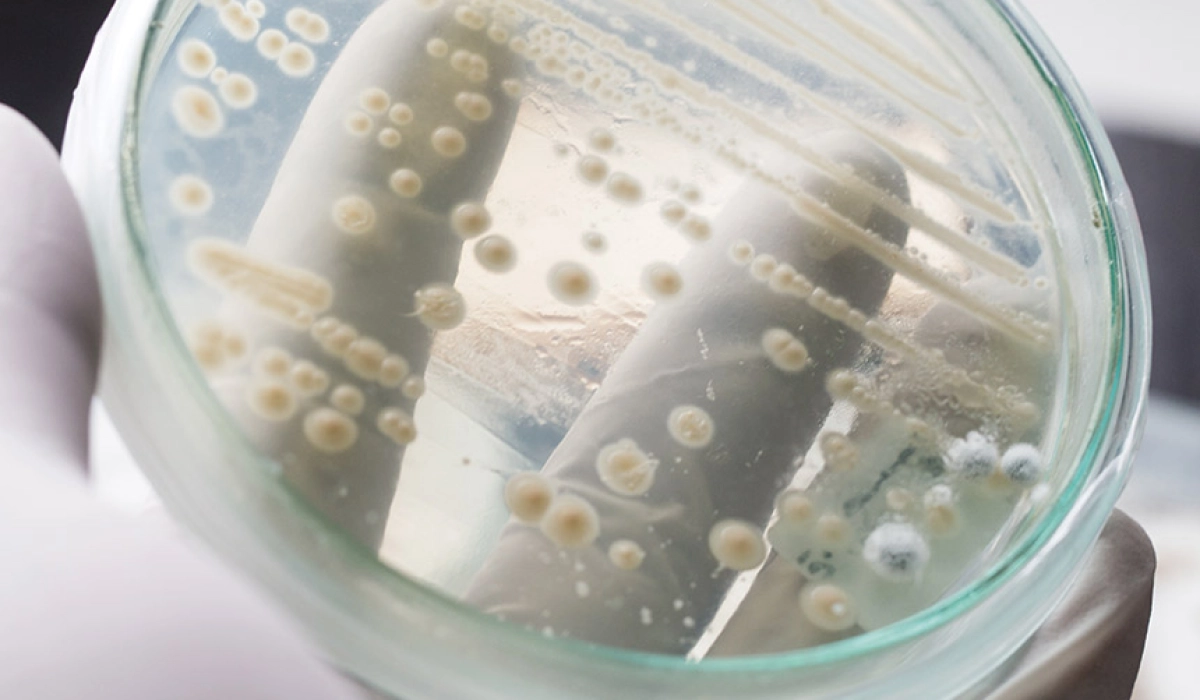
Преимущества пробиотиков в процессах гранулирования кормов: устойчивость и эффективность.

Преимущества пробиотиков в процессах гранулирования кормов: устойчивость и эффективность.
В современном производстве кормов дрожжевой пробиотик применяют в качестве ключевого компонента для улучшения качественных характеристик продукта. Это обусловлено их способностью выдерживать высокие температуры и механические воздействия, связанные с процессами гранулирования, такими как сжатие и трение.
В современном производстве кормов дрожжевой пробиотик применяют в качестве ключевого компонента для улучшения качественных характеристик продукта. Это обусловлено их способностью выдерживать высокие температуры и механические воздействия, связанные с процессами гранулирования, такими как сжатие и трение. Использование дрожжевых пробиотиков позволяет не только сохранить полезные свойства в готовом корме, но и обеспечить его устойчивость к негативным факторам окружающей среды.
Улучшение устойчивости корма и его пищевой ценности
Пробиотики играют важную роль в поддержании качества корма во время хранения и транспортировки. Включение дрожжевых пробиотиков в состав корма позволяет:
- Повысить его устойчивость к порче;
- Улучшить пищевую ценность благодаря сохранению биоактивных компонентов;
- Обеспечить лучшую усвояемость корма животными.
Вклад в здоровье животных
Пробиотики значительно влияют на здоровье животных, начиная с пищеварительной системы и заканчивая общим иммунитетом. Добавление дрожжевых пробиотиков в корма способствует:
- Улучшению баланса микрофлоры в рубце и кишечнике;
- Сокращению необходимости использования антибиотиков, снижая риск развития резистентности к антибиотикам у животных;
- Повышению общего уровня здоровья и продуктивности, что особенно важно в условиях высокой загрузки и стресса.
Экологическая безопасность и экономическая выгода
Использование дрожжевых пробиотиков в производстве кормов не только улучшает его качество и влияет на здоровье животных, но также предоставляет значительные экологические и экономические преимущества:
- Снижение отходов производства за счет более эффективного использования сырья;
- Повышение эффективности процессов производства кормов;
- Уменьшение экологического воздействия за счет натуральности компонентов и сокращения использования химических добавок.
Оптимизация питательного состава кормов
Пробиотики, включая дрожжевые, способствуют оптимизации питательного состава кормов за счет их биоактивных свойств. Это улучшает общее качество корма, делая его более подходящим для специфических потребностей различных видов животных. Эффективное использование пробиотиков помогает:
- Увеличивать содержание витаминов и минералов в корме;
- Стабилизировать уровень pH в рубце, что предотвращает развитие заболеваний пищеварительной системы;
- Улучшить конверсию корма, что приводит к более быстрому и здоровому росту животных.
Технологические аспекты применения пробиотиков в гранулировании
Интеграция дрожжевых пробиотиков в процесс гранулирования требует особого внимания к деталям производственного процесса. Технологии гранулирования должны быть адаптированы для обеспечения максимальной сохранности живых микроорганизмов. Основные моменты включают:
- Настройка температурных режимов гранулирования для предотвращения гибели пробиотических культур;
- Использование методов обработки, минимизирующих механическое воздействие на пробиотики;
- Разработка специальных добавок-носителей, которые помогают сохранять жизнеспособность пробиотиков в условиях высоких температур и давления.
Примеры успешного внедрения пробиотиков на производственных мощностях
Примеры из практики показывают, что успешное внедрение пробиотиков может значительно повысить эффективность производственных процессов. Некоторые производители кормов, внедрившие дрожжевые пробиотики, отмечают:
- Повышение уровня выживаемости молодняка благодаря улучшению качества корма;
- Снижение затрат на ветеринарные услуги за счет улучшения общего здоровья стада;
- Увеличение производительности животных на фоне повышенной усвояемости и питательной ценности кормов.